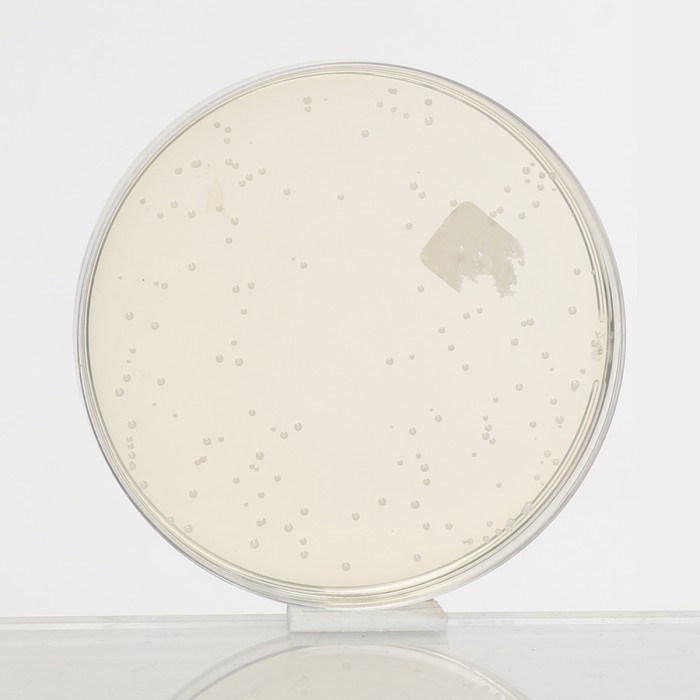
Rogosa SL Agar, Granulated

Your enquiry has been submitted
Thioglycollate Medium w/o Dextrose
Thioglycollate Medium without Dextrose is used for cultivation of aerobes, microaerophiles, anaerobes and for fermentation studies with various carbohydrates.
Composition**
| Ingredients | Gms / Litre |
|---|---|
| Casein enzymic hydrolysate | 20.000 |
| Sodium chloride | 2.500 |
| Dipotassium phosphate | 1.500 |
| Sodium thioglycollate | 0.600 |
| L-Cystine | 0.400 |
| Sodium sulphite | 0.200 |
| Methylene blue | 0.002 |
| Agar | 0.500 |
Final pH ( at 25°C): 7.2±0.2
**Formula adjusted, standardized to suit performance parameters
Directions
Suspend 25.7 grams in 1000 ml distilled water. If the medium is to be used for fermentation studies or for diagnostic work adds 0.5 to 1% carbohydrate of choice. Heat to boiling to dissolve the medium completely. Dispense and sterilize by autoclaving at 15 lbs pressure (121°C) for 15 minutes. Alternatively, sterile carbohydrate solutions may be added to the broth after sterilization. The prepared medium should be stored in the dark at room temperature.
Note: If more than the upper one-third has acquired a green colour, the medium may be restored once by heating in a waterbath or free flowing steam until the green colour disappears.
Principle And Interpretation
Thioglycollate Medium without Dextrose is the modification of original Thioglycollate medium (1, 2) used for the fermentation study of anaerobes and for enhancement of sporulation. Omission of dextrose facilitates it to be used in fermentation studies with the addition of desired carbohydrate. Some Clostridia remain viable for a longer period and sporulate better in the absence of carbohydrate and thus this medium could be used for sporulations.
Casein enzymic hydrolysate, L-cystine and salts provide essential nutrients like nitrogenous compounds, carbon, sulphur, minerals and amino acids. The reducing action provided by sodium thioglycollate and sodium sulphite binds molecular oxygen, thereby maintaining a low Eh (3). A small amount of agar is added to retard the absorption of oxygen by reducing convection currents in the medium. Methylene blue is a redox indicator.
Quality Control
Appearance: Cream to yellow homogeneous free flowing powder
Colour and Clarity of prepared medium: Light yellow coloured very slightly opalescent viscous solution with upper 10% or less medium green on standing
Reaction: Reaction of 2.57% w/v aqueous solution at 25°C. pH : 7.2±0.2
pH: 7.00-7.40
Cultural Response
M190: Cultural characteristics observed after an incubation at 35-37°C for 48 hours(in an appropriate atmosphere).
| Organism | Inoculum (CFU) | Growth |
|---|---|---|
| Bacillus subtilis ATCC 6633 | 50-100 | good |
| Bacteroides vulgatus ATCC 8482 | 50-100 | fair |
| Candida albicans ATCC 10231 | 50-100 | good |
| Clostridium sporogenes ATCC 11437 | 50-100 | good-luxuriant |
| Micrococcus luteus ATCC 10240 | 50-100 | good |
| Neisseria meningitidis ATCC 13090 | 50-100 | good |
| Streptococcus pyogenes ATCC 19615 | 50-100 | good-luxuriant |
Storage and Shelf Life
Store below 30°C and the prepared medium at 2-8°C. Use before expiry date on the label.
Reference
- Brewer J. H., 1940, J. Am Med. Assoc., 115, 598.
- Brewer J. H., 1940, J. Bacteriol., 39:10.
- MacFaddin J. F., 1985, Media for Isolation-Cultivation-Identification-Maintenance of Medical Bacteria, Vol.1 William and Wilkins, Baltimore.
| Product Name | Thioglycollate Medium w/o Dextrose |
|---|---|
| SKU | M190 |
| Product Type | Regular |
| Physical Form | Powder |
| Origin | Animal |
| Packaging type | HDPE |
| References | 1.Rogosa,J.,Mitchell J.A. and Wiseman,R.F.(1951)A selective medium for the isolation and enumeration of oral andfecal lactobacilli.J.Bacteriol.62,132-13 3. 2.ISO(1984)Drafts reports.Enumeration of Lactobacteriaceae in meat and meat products.ISO/TC 34/SC 6/WG 15,no.3and no. 5.International Organization for Standardization,Geneva. 3.Reuter,G. (1985)Elective and selective media for lactic acid bacteria .Int.J.Food Microbiol.2,55-6 4.MacFaddin J. F., 1985, Media for Isolation-Cultivation-Identification- Maintenance of Medical Bacteria, Vol. I, Williams and Wilkins, Baltimore. Md. 5.Sharpe M. L. (Ed.), 1960, Lab-Practice, 9(4): 223. |